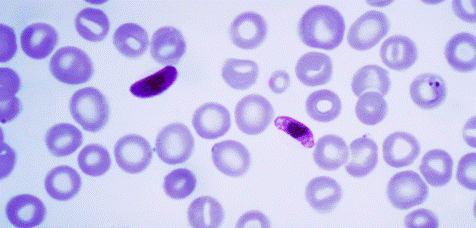

Ngày 18/10/2016. Malaria News-Sự 'thờ ơ' của Chính phủ làm gia tăng sốt rét tại Venezuela (Government ‘indifference’ leads to malaria surge in Venezuela, health officials charge). Chính phủ Venezuela không coi trọng các vấn đề y tế công cộng cấp bách nhất của đất nước nên điều đó có khả năng góp phần vào sự gia tăng đáng báo động về số ca mắc sốt rét trong năm nay.
Trong cuộc họp báo hôm thứ hai tuần qua, Douglas Leon Natera-Chủ tịch Liên đoàn y tế Venezuela cho biết quốc gia Nam Mỹ này đã báo cáo hơn 180.000 ca mắc sốt rét thời điểm này năm nay so với 136.402 ca mắc tại Venezuela cả năm 2015, trong đó 80% số ca ghi nhận ở bang Bolivar, con số này tăngcao trong vòng 75 năm trở lại đây. Theo Báo cáo sốt rét thế giới (World Malaria Report) năm 2015 của Tổ chức Y tế thế giới (WHO), Venezuela đầu tư chưa đầy một đô la (USD) cho mỗi người có nguy cơ mắc sốt rét-thấp thứ hai khu vực. Leon cho biết: "Chúng tôi kêu gọi Chính phủ cần có các biện pháp khắc phục cần thiết" và ông cho biết thêm rằng theo báo cáo của El Impulso các vấn đề y tế công cộng của đất nước đã diễn ra dưới cái nhìn thờ ơ của chính phủ: "Chúng tôi hiểu lý do chính trị che đậy tất cả mọi thứ nhưng không có nghĩa là không có các công cụ chẩn đoán sốt rét hiệu quả hơn".
|
Hình ảnh Plasmodium falciparum trên lam máu giọt đàn, gây sốt rét ác tính ở người ( Ảnh: US CDC) |
Venezuela được WHO chứng nhận tiêu diệt sốt rét (eradicated malaria) vào 1961, trước cả Hoa Kỳ 9 năm nhưng trong suốt thời kỳ Tổng thống xã hội chủ nghĩa Hugo Chavez và Tổng thống hiện nay Nicolás Maduro số ca mắc sốt rét gia tăng trở lại. Sự chậm giải quyết vấn đề khủng hoảng kinh tế ngày càng trầm trọng của chính quyền Maduro làm tê liệt đất nước, góp phần vào tình trạng thiếu hụt thuốc điều trị lan rộng và tác động đến nỗ lực tiêu diệt sốt rét những năm gần đây. Theo tổ chức bác sĩ không biên giới (MSF), điều tồi tệ hơn là Venezuela và các nước láng giềng đã chứng kiến một sự gia tăng đáng kể chủng ký sinh trùng sốt rét nguy hiểm nhất là P. falciparum. Sự gia tăng số mắc sốt rét ở Venezuela trong năm nay đang là chủ đề quan tâm của các chuyên gia y tế toàn cầu trong cuộc chiến sốt rét khi dịch bệnh này có nguy cơ lây lan sang nước láng giềng Colombia và Brazil. Tại cuộc họp báo này, Leon cũng đưa ra một cái nhìn tổng thể về các dịch bệnh khác đang gia tăng tại Venezuela thời gian gần đây, theo báo cáo El Impulso hàng năm cả nước đã ghi nhận hơn 83.000 ca mắc sốt xuất huyết dengue và 4.000 ca mắc lao (TB cases). Ông cũng bác bỏ tuyên bố của chính phủ về thực hiện tiêm chủng bệnh bạch hầu hàng loạt ở bang Bolívar, căn bệnh không còn xuất hiện ở Venezuela trong 25 năm qua đến khi các hiệp hội y tế công cộng địa phương thời gian gần đây báo cáo ít nhất 17 trường hợp. Theo Reuters, Thống đốc đảng cầm quyền bang Bolivar, Francisco Rangel viết trên Twitter rằng bang này sẽ tiêm chủng cho 400.000 người, trong khi Leon cho biết thực ra con số này chỉkhoảng 25 - 30 người được tiêm chủng mỗi ngày.